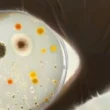

جدول المحتويات
- تحليل اللغة العربية: التركيب الصرفي
- معنى وتفسير المستوى الصرفي
- الصلة بين الصرف والصوتيات
- المورفولوجيا والمورفيم: أساسيات علم الصرف
- تصنيفات المورفيمات في اللغة العربية
- أمثلة عملية على المورفيمات
تحليل اللغة العربية: التركيب الصرفي
يُعرف التحليل اللغوي بأنه عملية تفكيك الجمل والكلمات إلى مكوناتها الأساسية لفهم بنيتها ومعناها. أحد أهم مستويات هذا التحليل هو ما يُعرف بالتحليل الصرفي، والذي يُركز على دراسة بنية الكلمة نفسها بمعزل عن سياقها الجُملية. هذا المجال يُعتبر حجر الأساس لفهم بناء اللغة العربية.
معنى وتفسير المستوى الصرفي
المستوى الصرفي هو فرع من فروع علم اللسانيات يُعنى بدراسة تركيب الكلمات، وتركيزه على الأشكال والوحدات الأصغر التي تُشكل الكلمة، وكيفية تكوينها، وبالتالي معناها الصرفي المباشر. في اللسانيات الحديثة، يُعرف هذا المجال باسم “المورفولوجيا”. يُعتبر المستوى الصرفي ركيزة أساسية في فهم اللغة، فهو مترابط مع غيره من المستويات اللغوية ولا يُمكن فهمه بمعزل عنها. وقد وصف ابن جنيّ الصرف بأنه “صعب المسلك ودقيق المأخذ”، وهذا يدل على تعقيده ودقته.
الصلة بين الصرف والصوتيات
يؤكد العديد من علماء اللغة، أمثال أحمد مختار عمر وتمام حسن، على أهمية الربط بين المستوى الصرفي والمستوى الصوتي. فالمستوى الصوتي يُعتبر الخطوة الأولى في أي دراسة لغوية، سواء كانت صرفية أو نحوية. دراسة الصرف ضمن تسلسل منطقي تبدأ بالتحليل الصوتي، ثم البنية الصرفية، ثم التركيب النحوي، وأخيراً الدلالة المعنوية.
المورفولوجيا والمورفيم: أساسيات علم الصرف
كما ذكرنا سابقاً، يُعرف المستوى الصرفي في اللسانيات الحديثة بالمورفولوجيا. ومن هذا المصطلح يُشتق مصطلح “المورفيم”، وهو أصغر وحدة صرفية مستقلة تحمل معنىً بذاتها. وقد لاقى مصطلح “المورفيم” قبولاً واسعاً بين اللسانيين العرب، على الرغم من وجود محاولات لتعريبه، إلا أن هذه المحاولات لم تُحقق المعنى المطلوب.
تصنيفات المورفيمات في اللغة العربية
تنقسم المورفيمات في اللغة العربية إلى ثلاثة أنواع رئيسية:
- المورفيم الحر: وهو وحدة صرفية مستقلة بذاتها، تحمل معنىً كاملاً، مثل حروف الجر (من، إلى، عن،…)، والضمائر المنفصلة (أنا، أنت، هو،…)، وأفعال الشروع (شرع، أنشأ،…).
- المورفيم المقيد: وهو وحدة صرفية غير مستقلة، تعتمد على مورفيم حر لتكوين معنىً، مثل أل التعريف، ألف الاثنين، واو الجماعة، علامات الإعراب، وأحرف المضارعة.
- المورفيم الصفري: وهو مورفيم لا يُكتب ولا يُسمع، ولكنه موجود في التركيب الذهني للجملة، مثل الضمائر المستترة في الجمل، والإسناد في الجمل، والصيغ في المشتقات.
أمثلة عملية على المورفيمات
لنأخذ الجملة التالية مثالاً: “الطفلُ يجلسُ في الحديقةِ”.
- الطفلُ: “ال” مورفيم مقيد (أل التعريف)، “طفل” مورفيم حر، وعلامة الضمة مورفيم مقيد.
- يجلسُ: “ي” مورفيم مقيد (حرف المضارعة)، “جلس” مورفيم حر، وعلامة الضمة مورفيم مقيد.
- في: مورفيم حر (حرف جر).
- الحديقةِ: “ال” مورفيم مقيد (أل التعريف)، “حديقة” مورفيم حر، وعلامة الكسرة مورفيم مقيد.
- ضمير مستتر “هو” في “يجلس” يُعتبر مورفيمًا صفريًا.
هذه الأمثلة توضح كيفية تحليل الكلمات إلى مكوناتها الصرفية المختلفة، وكيفية تفاعل هذه المكونات لتكوين معنىً كاملًا.